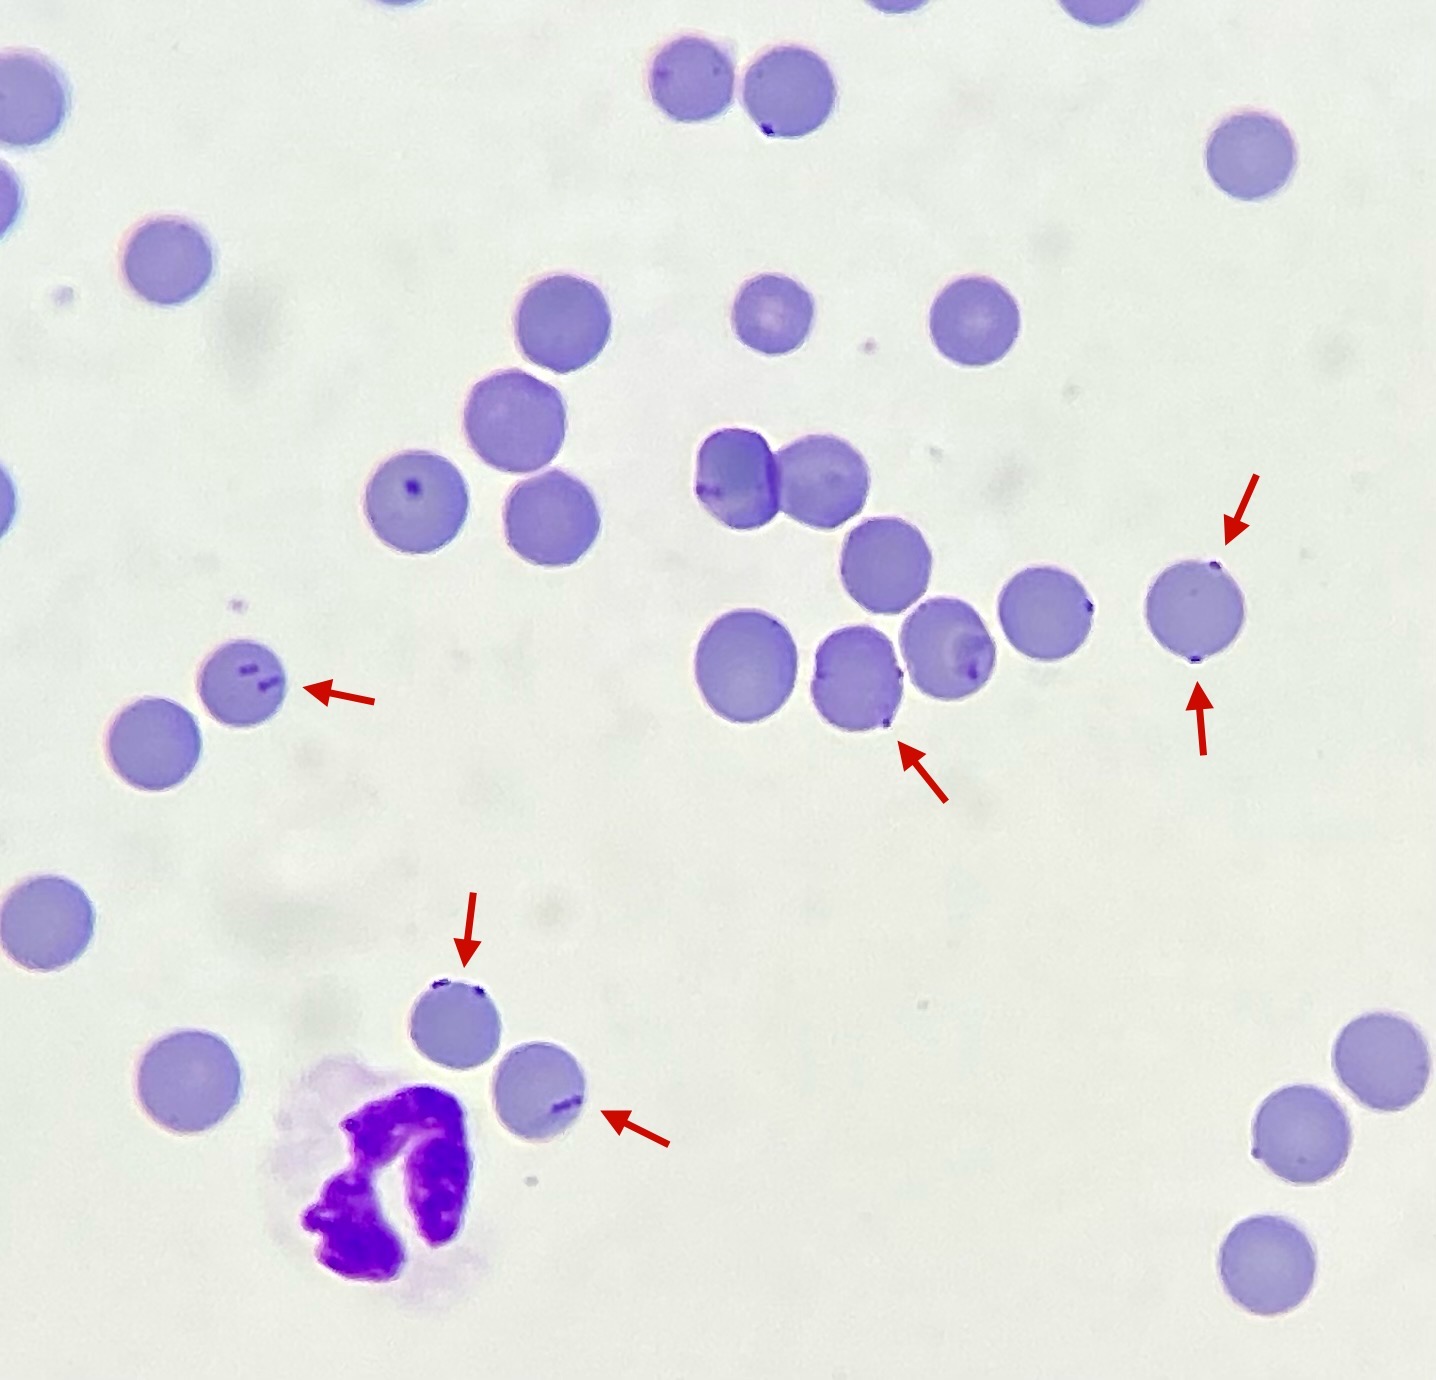

El mundo bajo el microscopio
Querido compañero, te presentamos una serie de imágenes vistas a través del microscopio.
Iniciamos esta sección con la visualización de Micoplasmas hemotrópicos en perros y gatos (antes hemobartonelas) mediante microscopía, orientadas a la formación y actualización en histopatología.
Mycoplasma haemofelis
Los micoplasmas hemotrópicos son bacterias gramnegativas que se adhieren a la superficie de los eritrocitos. En los gatos se han descrito hasta ahora tres especies diferentes con distintos grados de patogenicidad: Mycoplasma haemofelis, Mycoplasma haemominutum y Mycoplasma turicensis. En perros se conocen dos especies diferentes: Mycoplasma haemocanis y Mycoplasma haematoparvum.
La vía de transmisión aún no se ha aclarado con certeza, pero se cree que la transmisión se produce a través de vectores (principalmente pulgas y garrapatas). En animales inmunocompetentes, la infección suele ser asintomática (¡excepto M. haemofelis!). Las enfermedades graves y la anemia hemolítica se producen principalmente en animales inmunodeprimidos, esplenectomizados o infectados simultáneamente con otros patógenos (por ejemplo, babesiosis, ehrlichiosis, FeLV, FIV).
Aunque es posible detectarlos al microscopio, esta técnica es poco sensible. Por lo tanto, siempre se debe confirmar la sospecha mediante PCR. Debido a la diferente patogenicidad, es aconsejable diferenciar las especies.
Al microscopio, los micoplasmas se reconocen como pequeñas estructuras azules y redondas en la superficie de los eritrocitos. A veces también son visibles como estructuras anulares u oblongas.
Esperamos que hayas disfrutado de esta sección.
¡Te esperamos en la próxima!
Tu equipo LABOKLIN España